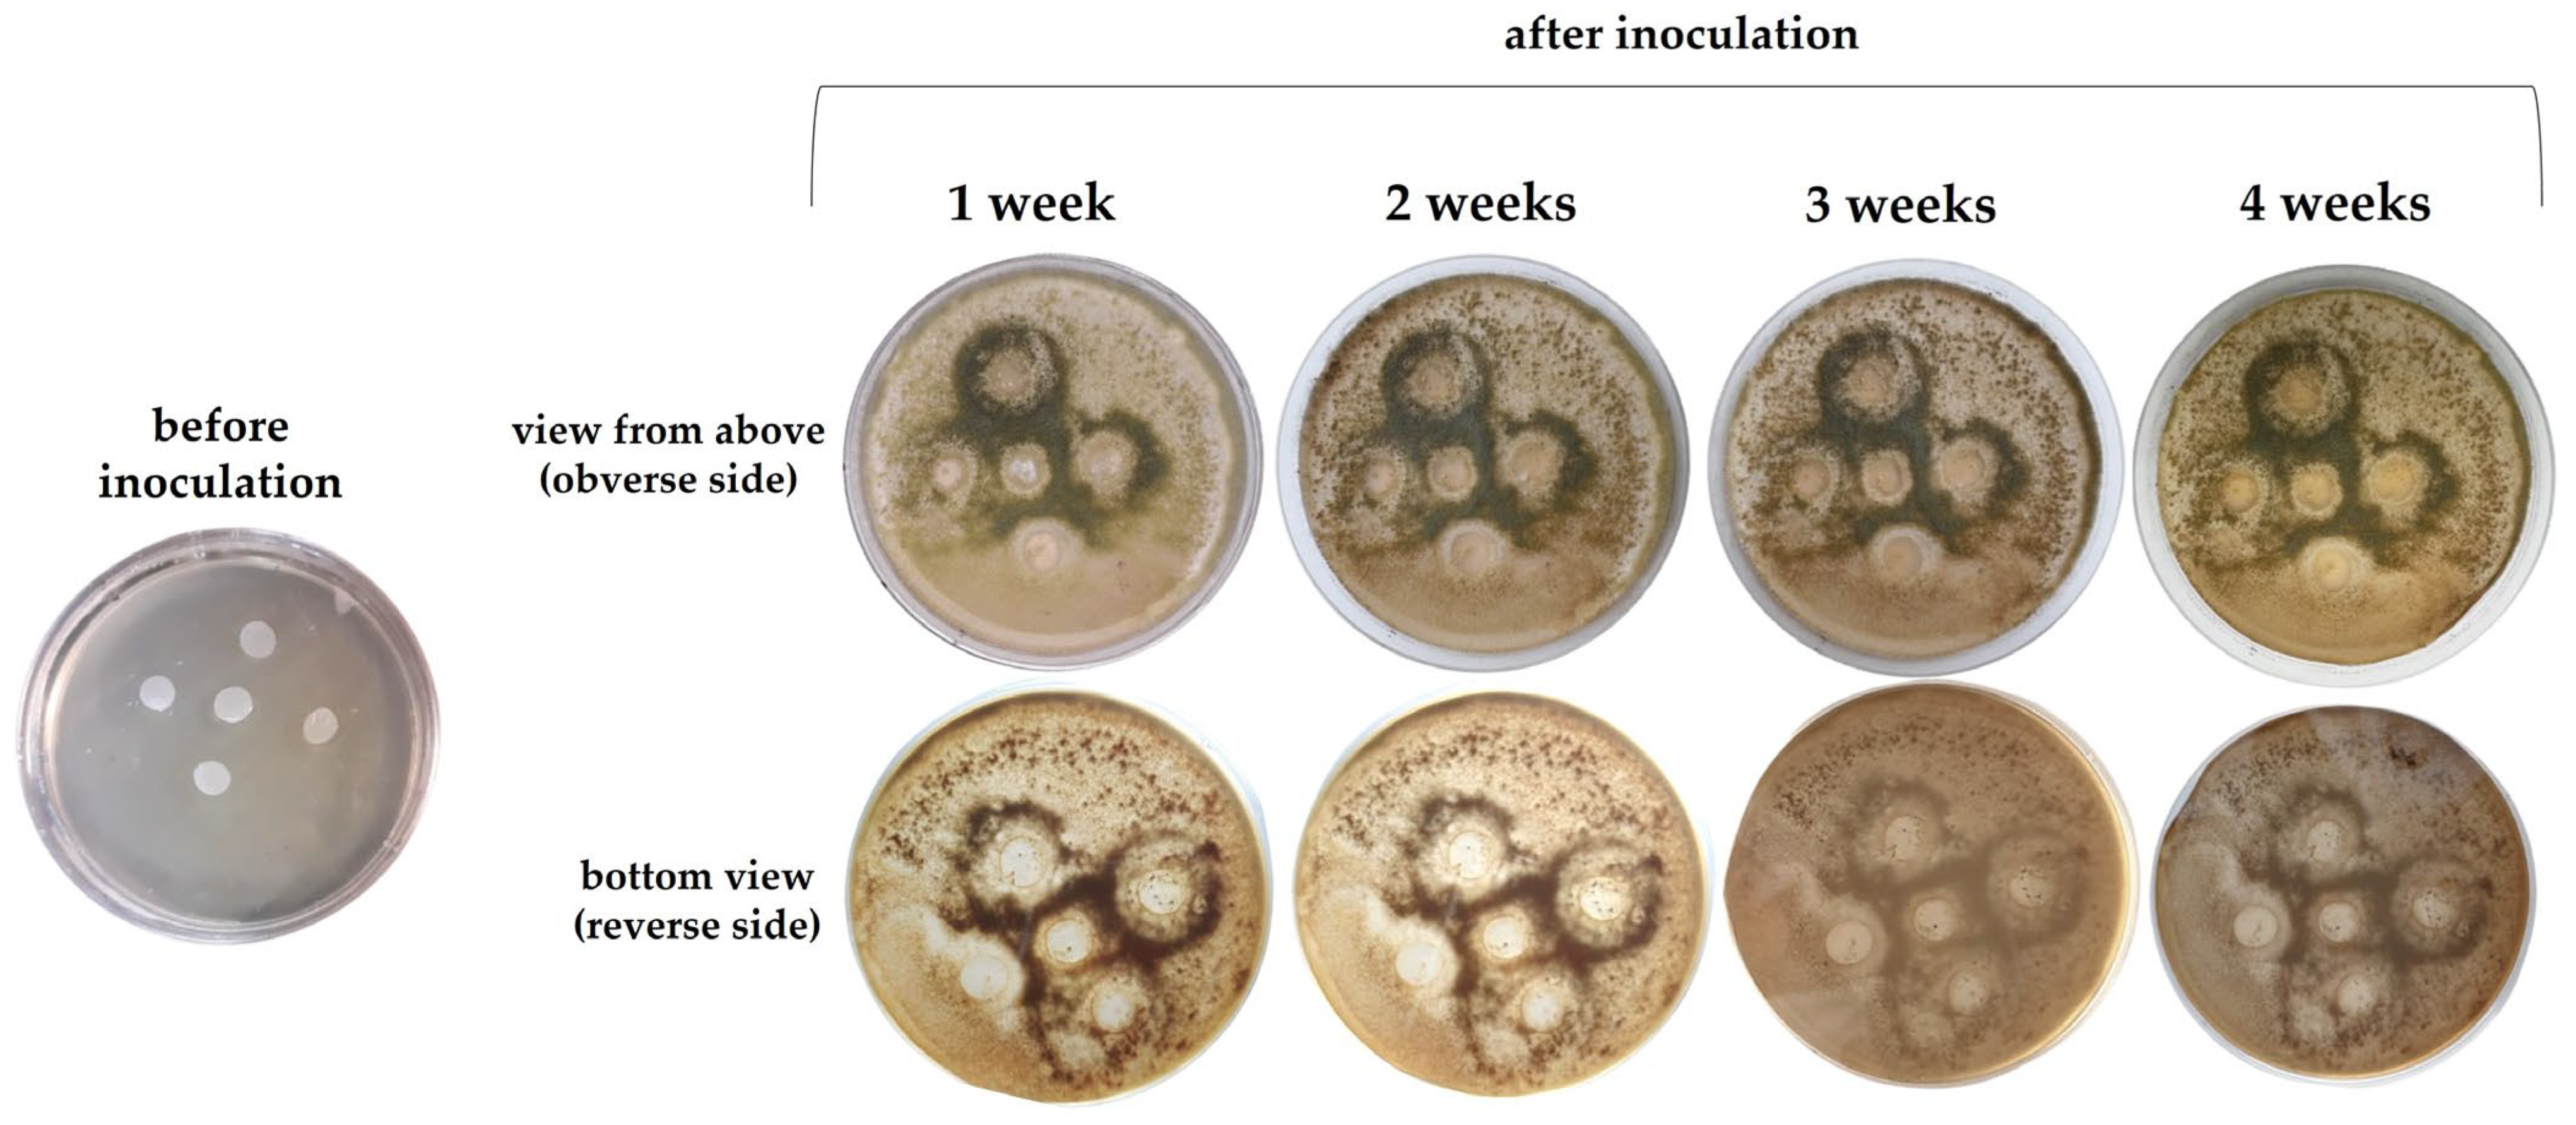
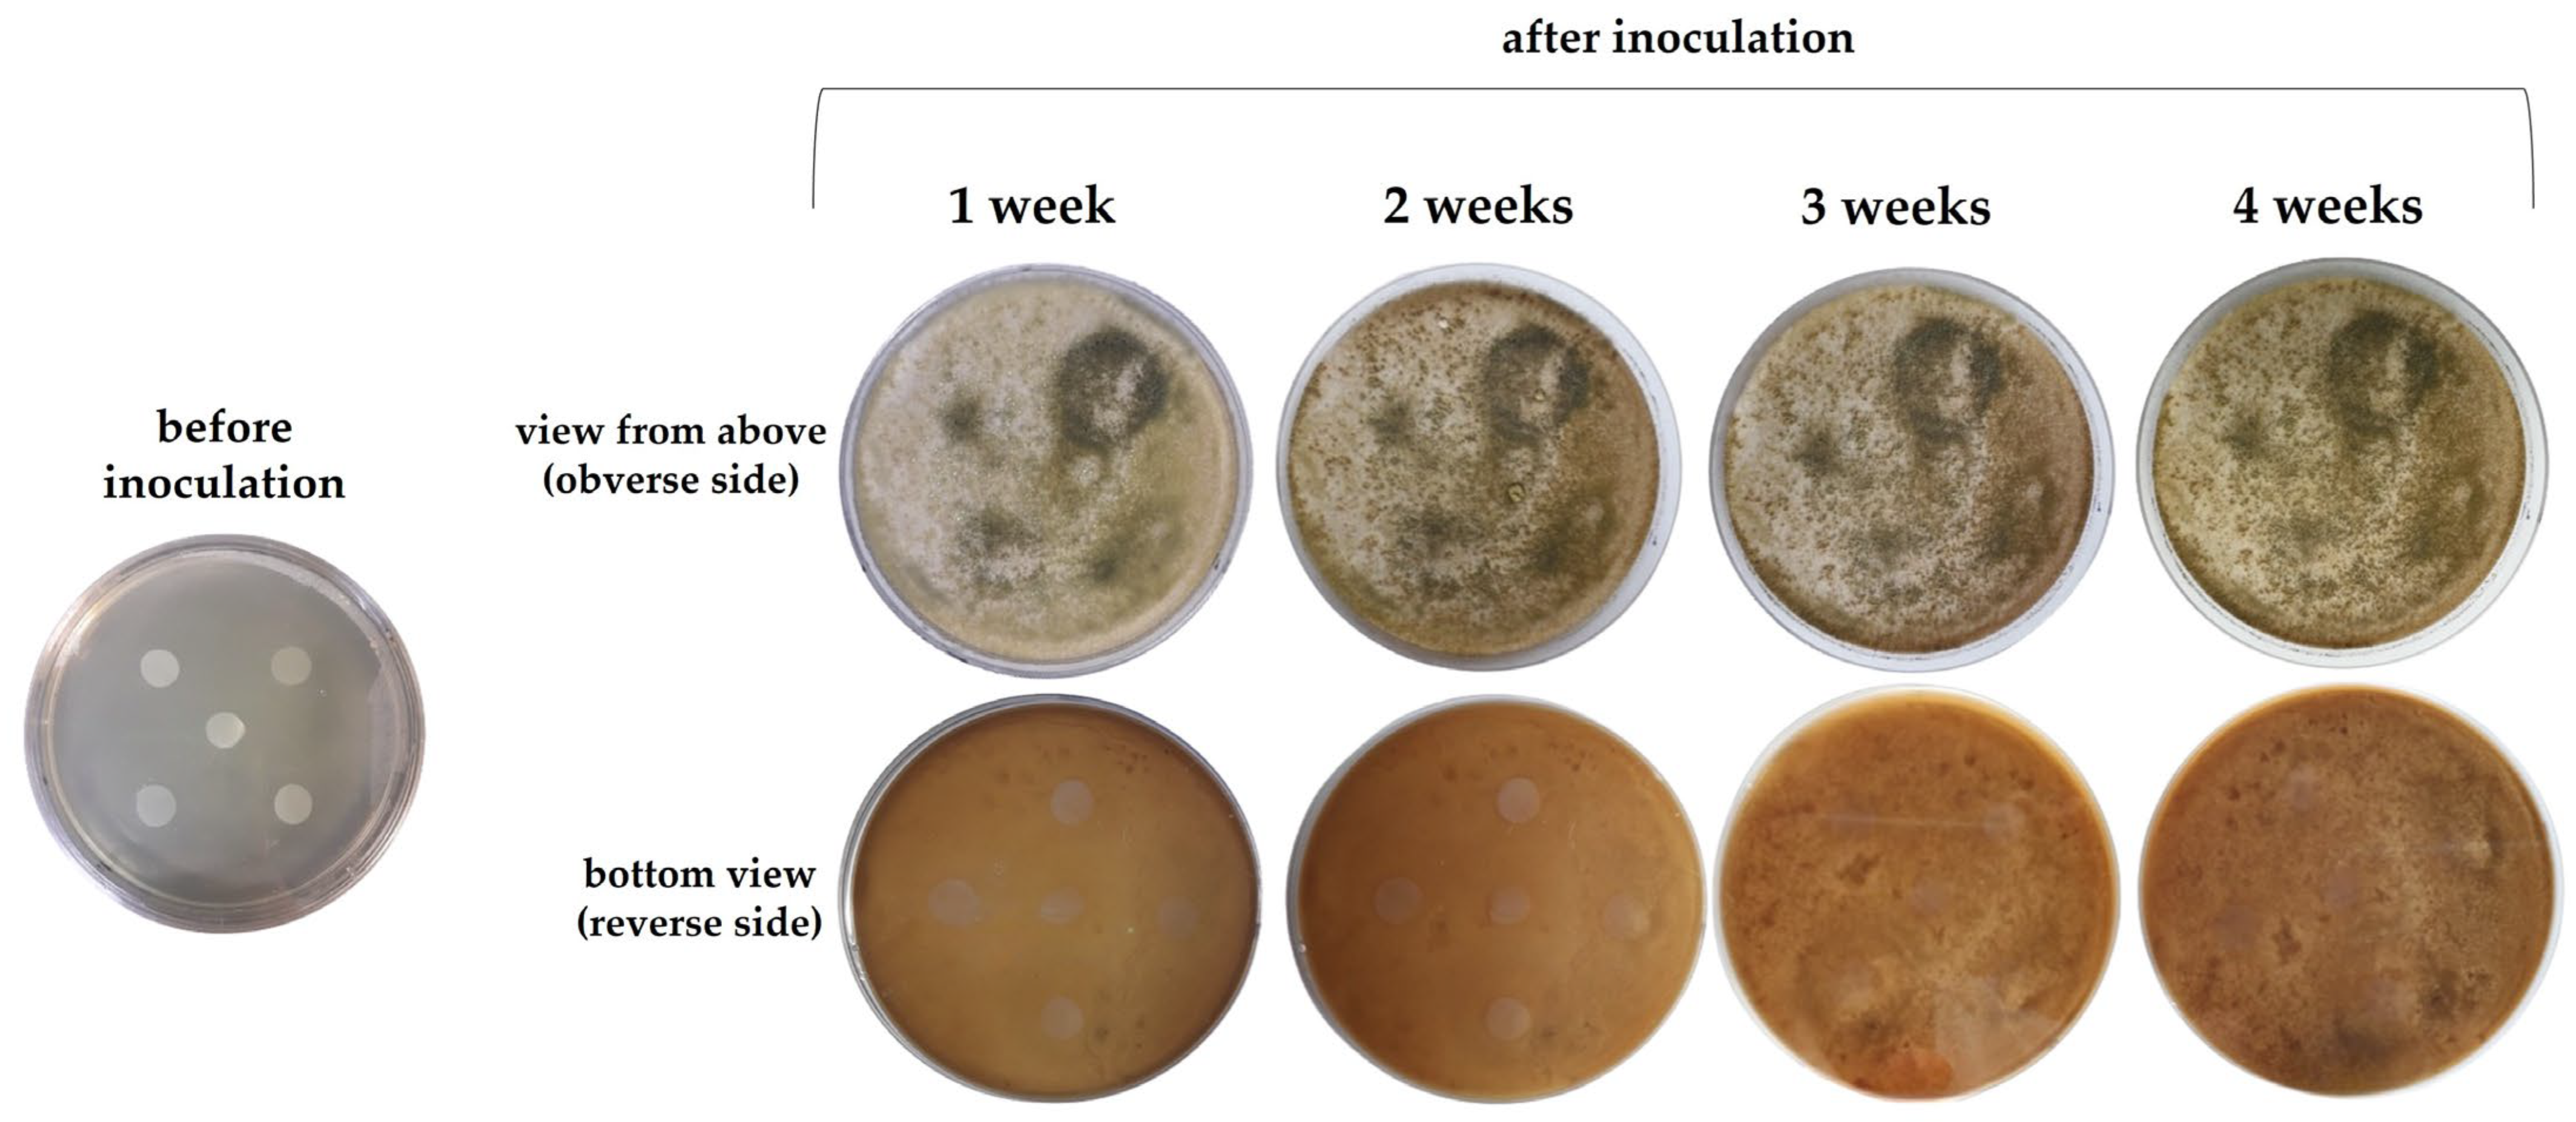

Evaluation of Film-Forming Properties of α-1,3-Glucan Obtained from “Chicken of the Woods” Mushroom (Laetiporus sulphureus): Film Development, Characterization, and Biodegradation Assessment
Abstract
1. Introduction
2. Results and Discussion
2.1. Microscopic Features of the Film-Forming Solution (FFS) and Film
2.2. Structural Features of the Film
2.3. Physiochemical Properties of the Film
2.4. Action of Microorganisms on the Film
2.5. Susceptibility of the Film to Degradation
3. Materials and Methods
3.1. Preparation of α-1,3-GLU
3.2. Optimization of Plasticizer Concentration and Heating Temperature
3.3. Film Preparation
3.4. Analysis of Film Properties
3.4.1. Film Thickness and Conditioning
3.4.2. Microstructure
3.4.3. Attenuated Total Reflection–Fourier Transform Infrared (ATR-FTIR) Spectroscopy
3.4.4. Raman Spectroscopy and Surface Mapping
3.4.5. Wide-Angle X-Ray Diffraction (WAXD)
3.4.6. Physicochemical Properties
3.4.7. Evaluation of the Action of Microorganisms
3.4.8. Susceptibility of the Film to Degradation by Trichoderma harzianum
3.4.9. Enzymatic Breakdown of the Film
4. Conclusions
Author Contributions
Funding
Institutional Review Board Statement
Informed Consent Statement
Data Availability Statement
Conflicts of Interest
Abbreviations
| α-1,3-GLU | α-1,3-glucan |
| ATR-FTIR | attenuated total reflection–Fourier transform infrared |
| aw | water activity |
| CFUs | colony-forming units |
| DIC | differential interference contrast |
| EB | elongation at break |
| EM | elastic modulus |
| FFS | film-forming solution |
| LT | light transmission |
| MC | moisture content |
| Op | opacity |
| PDA | potato dextrose agar |
| PS | puncture strength |
| Rq | root-mean-square roughness |
| SEM | scanning electron microscopy |
| So | solubility |
| Sw | swelling |
| TS | tensile strength |
| WAXD | wide-angle X-ray diffraction |
| WCA | water contact angle |
| WVP | water vapor permeability |
| Xc | degree of crystallinity |
| γL | surface energy |
References
- Dirpan, A.; Ainani, A.F.; Djalal, M. A Review on Biopolymer-Based Biodegradable Film for Food Packaging: Trends over the Last Decade and Future Research. Polymers 2023, 15, 2781. [Google Scholar] [CrossRef] [PubMed]
- Mansoor, Z.; Tchuenbou-Magaia, F.; Kowalczuk, M.; Adamus, G.; Manning, G.; Parati, M.; Radecka, I.; Khan, H. Polymers Use as Mulch Films in Agriculture—A Review of History, Problems and Current Trends. Polymers 2022, 14, 5062. [Google Scholar] [CrossRef] [PubMed]
- Kalpana Manivannan, R.; Sharma, N.; Kumar, V.; Jayaraj, I.; Vimal, S.; Umesh, M. A comprehensive review on natural macromolecular biopolymers for biomedical applications: Recent advancements, current challenges, and future outlooks. Carbohydr. Polym. Technol. Appl. 2024, 8, 100536. [Google Scholar] [CrossRef]
- Mendoza-Muñoz, N.; Leyva-Gómez, G.; Piñón-Segundo, E.; Zambrano-Zaragoza, M.L.; Quintanar-Guerrero, D.; Del Prado Audelo, M.L.; Urbán-Morlán, Z. Trends in biopolymer science applied to cosmetics. Int. J. Cosmet. Sci. 2023, 45, 699–724. [Google Scholar] [CrossRef]
- Sabu Mathew, S.; Jaiswal, A.K.; Jaiswal, S. A comprehensive review on hydrophobic modification of biopolymer composites for food packaging applications. Food Packag. Shelf Life 2025, 48, 101464. [Google Scholar] [CrossRef]
- Jamróz, E.; Kulawik, P.; Kopel, P. The effect of nanofillers on the functional properties of biopolymer-based films: A review. Polymers 2019, 11, 675. [Google Scholar] [CrossRef]
- Pomoni, D.I.; Koukou, M.K.; Vrachopoulos, M.G.; Vasiliadis, L. Circular economy: A multilevel approach for natural resources and wastes under an agri-food perspective. Water-Energy Nexus 2024, 7, 103–123. [Google Scholar] [CrossRef]
- Azadi, E.; Dinari, M.; Derakhshani, M.; Reid, K.R.; Karimi, B. Sources and extraction of biopolymers and manufacturing of bio-based nanocomposites for different applications. Molecules 2024, 29, 4406. [Google Scholar] [CrossRef]
- Aiduang, W.; Jatuwong, K.; Jinanukul, P.; Suwannarach, N.; Kumla, J.; Thamjaree, W.; Teeraphantuvat, T.; Waroonkun, T.; Oranratmanee, R.; Lumyong, S. Sustainable Innovation: Fabrication and Characterization of Mycelium-Based Green Composites for Modern Interior Materials Using Agro-Industrial Wastes and Different Species of Fungi. Polymers 2024, 16, 550. [Google Scholar] [CrossRef]
- Corbu, V.M.; Gheorghe-Barbu, I.; Dumbravă, A.Ș.; Vrâncianu, C.O.; Șesan, T.E. Current Insights in Fungal Importance—A Comprehensive Review. Microorganisms 2023, 11, 1384. [Google Scholar] [CrossRef]
- Łysakowska, P.; Sobota, A.; Wirkijowska, A. Medicinal Mushrooms: Their Bioactive Components, Nutritional Value and Application in Functional Food Production—A Review. Molecules 2023, 28, 5393. [Google Scholar] [CrossRef]
- Flores, G.A.; Cusumano, G.; Venanzoni, R.; Angelini, P. The Glucans Mushrooms: Molecules of Significant Biological and Medicinal Value. Polysaccharides 2024, 5, 212–224. [Google Scholar] [CrossRef]
- Leong, Y.K.; Yang, F.-C.; Chang, J.-S. Extraction of polysaccharides from edible mushrooms: Emerging technologies and recent advances. Carbohydr. Polym. 2021, 251, 117006. [Google Scholar] [CrossRef] [PubMed]
- Lindner, D.L.; Banik, M.T. Molecular phylogeny of Laetiporus and other brown rot polypore genera in North America. Mycologia 2008, 100, 417–430. [Google Scholar] [CrossRef]
- Złotko, K.; Wiater, A.; Waśko, A.; Pleszczyńska, M.; Pleszczyńska, P.; Paduch, R.; Jaroszuk-Ściseł, J.; Bieganowski, A.; Majtan, J. A Report on Fungal (1→3)-α-d-Glucans: Properties, Functions and Application. Molecules 2019, 24, 3972. [Google Scholar] [CrossRef]
- Khatua, S.; Ghosh, S.; Acharya, K. Laetiporus sulphureus (Bull.: Fr.) Murr. as Food as Medicine. Pharmacogn. J. 2017, 9, s1–s15. [Google Scholar] [CrossRef]
- Grün, C.; Hochstenbach, F.; Humbel, B.; Verkleij, A.; Sietsma, J.; Klis, F.; Kamerling, J.; Vliegenthart, J. The structure of cell wall -glucan from fission yeast. Glycobiology 2005, 15, 245–257. [Google Scholar] [CrossRef]
- Dennes, T.J.; Massouda, D.F.; Mishra, V.; Petricone, A.M. Production of Poly Alpha-1,3-Glucan Formate Films. WO2015109066A1, 23 July 2015. [Google Scholar]
- Mishra, V.; Dennes, T.J. Production of Poly Alpha-1,3-Glucan Films. WO2015200589A1, 30 December 2015. [Google Scholar]
- Paullin, R.B.K.L. Preparation of Poly Alpha-1,3-Glucan Esters and Films Therefrom. US20140187766A1, 26 June 2014. [Google Scholar]
- INCI Beuty. Alpha-Glucan Hydroxypropyltrimonium Chloride—Ingredient INCI Beauty. Available online: https://incibeauty.com/en/ingredients/125786-alpha-glucan-hydroxypropyltrimonium-chloride (accessed on 20 December 2024).
- Łupina, K.; Kowalczyk, D.; Zięba, E.; Kazimierczak, W.; Mężyńska, M.; Basiura-Cembala, M.; Wiącek, A.E. Edible films made from blends of gelatin and polysaccharide-based emulsifiers—A comparative study. Food Hydrocoll. 2019, 96, 555–567. [Google Scholar] [CrossRef]
- Kowalczyk, D.; Szymanowska, U.; Skrzypek, T.; Basiura-Cembala, M.; Materska, M.; Łupina, K. Corn starch and methylcellulose edible films incorporated with fireweed (Chamaenerion angustifolium L.) extract: Comparison of physicochemical and antioxidant properties. Int. J. Biol. Macromol. 2021, 190, 969–977. [Google Scholar] [CrossRef]
- Kowalczyk, D.; Karaś, M.; Kordowska-Wiater, M.; Skrzypek, T.; Kazimierczak, W. Inherently acidic films based on chitosan lactate-doped starches and pullulan as carries of nisin: A comparative study of controlled-release and antimicrobial properties. Food Chem. 2023, 404, 134760. [Google Scholar] [CrossRef]
- Miller-Chou, B.A.; Koenig, J.L. A review of polymer dissolution. Prog. Polym. Sci. 2003, 28, 1223–1270. [Google Scholar] [CrossRef]
- Poon, K.; Castellino, V.; Cheng, Y.L. Polymeric hydrophilic polymers in targeted drug delivery. In Artificial Cells, Cell Engineering and Therapy; Woodhead Publishing: Sawston, UK, 2007; pp. 42–71. ISBN 9781845690366. [Google Scholar]
- Li, Q.; Wang, A.; Ding, W.; Zhang, Y. Influencing Factors for Alkaline Degradation of Cellulose. BioResources 2017, 12, 1263–1272. [Google Scholar] [CrossRef]
- Whistler, R.L.; BeMiller, J.N. Alkaline Degradation of Polysaccharides. Adv. Carbohydr. Chem. 1958, 13, 289–329. [Google Scholar] [CrossRef]
- Cheng, X.W.; Huang, Y.T.; Zhang, C.; Gu, W.W.; Ma, Y.D.; Shi, F.Y.; Guan, J.P. Caramel product from glucose as a sustainable and effective flame retardant for silk fabric. J. Clean. Prod. 2020, 266, 121977. [Google Scholar] [CrossRef]
- Qin, Y.; Zhang, H.; Dai, Y.; Hou, H.; Dong, H. Effect of Alkali Treatment on Structure and Properties of High Amylose Corn Starch Film. Materials 2019, 12, 1705. [Google Scholar] [CrossRef]
- Łupina, K.; Kowalczyk, D.; Lis, M.; Basiura-Cembala, M. Antioxidant polysaccharide/gelatin blend films loaded with curcumin—A comparative study. Int. J. Biol. Macromol. 2023, 236, 123945. [Google Scholar] [CrossRef]
- Kowalczyk, D.; Karaś, M.; Kazimierczak, W.; Skrzypek, T.; Wiater, A.; Bartkowiak, A.; Basiura-Cembala, M. A Comparative Study on the Structural, Physicochemical, Release, and Antioxidant Properties of Sodium Casein and Gelatin Films Containing Sea Buckthorn Oil. Polymers 2025, 17, 320. [Google Scholar] [CrossRef]
- Ma, Y.; He, H.; Wu, J.; Wang, C.; Chao, K.; Huang, Q. Assessment of Polysaccharides from Mycelia of genus Ganoderma by Mid-Infrared and Near-Infrared Spectroscopy. Sci. Rep. 2018, 8, 10. [Google Scholar] [CrossRef]
- Gupta, B.S.; Jelle, B.P.; Gao, T. Application of ATR-FTIR Spectroscopy to Compare the Cell Materials of Wood Decay Fungi with Wood Mould Fungi. Int. J. Spectrosc. 2015, 2015, 521938. [Google Scholar] [CrossRef]
- Mohaček-Grošev, V.; Božac, R.; Puppels, G.J. Vibrational spectroscopic characterization of wild growing mushrooms and toadstools. Spectrochim. Acta Part A Mol. Biomol. Spectrosc. 2001, 57, 2815–2829. [Google Scholar] [CrossRef]
- Upadhyay, T.; Fatima, N.; Sharma, D.; Saravanakumar, V.; Sharma, R. Preparation and characterization of beta-glucan particles containing a payload of nanoembedded rifabutin for enhanced targeted delivery to macrophages. EXCLI J. 2017, 16, 210–228. [Google Scholar] [CrossRef] [PubMed]
- Guimarães, J.L.; Cursino, A.C.T.; Saul, C.K.; Sierrakowski, M.R.; Ramos, L.P.; Satyanarayana, K.G. Evaluation of Castor Oil Cake Starch and Recovered Glycerol and Development of “Green” Composites Based on Those with Plant Fibers. Materials 2016, 9, 76. [Google Scholar] [CrossRef] [PubMed]
- Synytsya, A.; Novak, M. Structural analysis of glucans. Ann. Transl. Med. 2014, 2, 17. [Google Scholar] [CrossRef] [PubMed]
- Zechner-Krpan, V.; Petravic-Tominac, V.; Gospodaric, I.; Sajli, L.; Djaković, S.; Filipovic-Grcic, J. Characterization of beta-Glucans Isolated from Brewer’s Yeast and Dried by Different Methods. Food Technol. Biotechnol. 2010, 48, 189–197. [Google Scholar]
- Sumayya, A.; Panicker, C.Y.; Varghese, H.; Harikumar, B. Vibrational spectroscopic studies and AB initio calculations of L-glutamic acid 5-amide. Rasayan J. Chem. 2008, 1, 548–555. [Google Scholar]
- Noothalapati, H.; Sasaki, T.; Kaino, T.; Kawamukai, M.; Ando, M.; Hamaguchi, H.-O.; Yamamoto, T. Label-free Chemical Imaging of Fungal Spore Walls by Raman Microscopy and Multivariate Curve Resolution Analysis. Sci. Rep. 2016, 6, 27789. [Google Scholar] [CrossRef]
- Mangolim, C.S.; da Silva, T.T.; Fenelon, V.C.; do Nascimento, A.; Sato, F.; Matioli, G. Use of FT-IR, FT-Raman and thermal analysis to evaluate the gel formation of curdlan produced by Agrobacterium sp. IFO 13140 and determination of its rheological properties with food applicability. Food Chem. 2017, 232, 369–378. [Google Scholar] [CrossRef]
- Huang, Y.-S.; Karashima, T.; Yamamoto, M.; Hamaguchi, H. Molecular-Level Investigation of the Structure, Transformation, and Bioactivity of Single Living Fission Yeast Cells by Time- and Space-Resolved Raman Spectroscopy. Biochemistry 2005, 44, 10009–10019. [Google Scholar] [CrossRef]
- Corbett, E.C.; Zichy, V.; Goral, J.; Passingham, C. Fourier transform Raman studies of materials and compounds of biological importance—II. The effect of moisture on the molecular structure of the alpha and beta anomers of d-glucose. Spectrochim. Acta Part A Mol. Spectrosc. 1991, 47, 1399–1411. [Google Scholar] [CrossRef]
- Nasdala, L.; Grotzschel, R.; Probst, S.; Bleisteiner, B. Irradiation damage in monazite-(Ce): An example to establish the limits of raman confocality and depth resolution. Can. Mineral. 2010, 48, 351–359. [Google Scholar] [CrossRef]
- Farrag, Y.; Barral, L.; Gualillo, O.; Moncada, D.; Montero, B.; Rico, M.; Bouza, R. Effect of Different Plasticizers on Thermal, Crystalline, and Permeability Properties of Poly(3–hydroxybutyrate–co−3–hydroxyhexanoate) Films. Polymers 2022, 14, 3503. [Google Scholar] [CrossRef] [PubMed]
- Dong, Z.; Zhang, P.; Kralj, S.; Ji, Y.; Schwaneberg, U. Synergism of Endo and Exo-α-1,3-Glucanases in α-1,3-Glucan Degradation: A Kinetic Study. ACS Sustain. Chem. Eng. 2024, 12, 9123–9132. [Google Scholar] [CrossRef]
- Kowalczyk, D.; Kazimierczak, W.; Zięba, E.; Mężyńska, M.; Basiura-Cembala, M.; Lisiecki, S.; Karaś, M.; Baraniak, B. Ascorbic acid- and sodium ascorbate-loaded oxidized potato starch films: Comparative evaluation of physicochemical and antioxidant properties. Carbohydr. Polym. 2018, 181, 317–326. [Google Scholar] [CrossRef]
- Kowalczyk, D.; Szymanowska, U.; Skrzypek, T.; Basiura-Cembala, M.; Łupina, K.; Biendl, M. Edible films based on gelatin, carboxymethyl cellulose, and their blends as carriers of potassium salts of iso-α-acids: Structural, physicochemical and antioxidant properties. Food Hydrocoll. 2021, 115, 106574. [Google Scholar] [CrossRef]
- Lin, Y.; Bilotti, E.; Bastiaansen, C.W.M.; Peijs, T. Transparent semi-crystalline polymeric materials and their nanocomposites: A review. Polym. Eng. Sci. 2020, 60, 2351–2376. [Google Scholar] [CrossRef]
- Chen, H.J.; Lee, P.Y.; Chen, C.Y.; Huang, S.L.; Huang, B.W.; Dai, F.J.; Chau, C.F.; Chen, C.S.; Lin, Y.S. Moisture retention of glycerin solutions with various concentrations: A comparative study. Sci. Rep. 2022, 12, 10232. [Google Scholar] [CrossRef]
- Tarique, J.; Sapuan, S.M.; Khalina, A. Effect of glycerol plasticizer loading on the physical, mechanical, thermal, and barrier properties of arrowroot (Maranta arundinacea) starch biopolymers. Sci. Rep. 2021, 11, 13900. [Google Scholar] [CrossRef]
- Kowalczyk, D.; Baraniak, B. Effects of plasticizers, pH and heating of film-forming solution on the properties of pea protein isolate films. J. Food Eng. 2011, 105, 295–305. [Google Scholar] [CrossRef]
- Shaw, N.B.; Monahan, F.J.; O’Riordan, E.D.; O’Sullivan, M. Physical Properties of WPI Films Plasticized with Glycerol, Xylitol, or Sorbitol. J. Food Sci. 2002, 67, 164–167. [Google Scholar] [CrossRef]
- Getahun, E.; Gabbiye, N.; Delele, M.A.; Fanta, S.W.; Gebrehiwot, M.G.; Vanierschot, M. Effect of maturity on the moisture sorption isotherm of chili pepper (Mareko Fana variety). Heliyon 2020, 6, e04608. [Google Scholar] [CrossRef]
- Żołek-Tryznowska, Z.; Holica, J. Starch films as an environmentally friendly packaging material: Printing performance. J. Clean. Prod. 2020, 276, 124265. [Google Scholar] [CrossRef]
- Donnet, J.-B.; Qin, R.-Y. Empirical estimation of surface energies of polymers and their temperature dependence. J. Colloid Interface Sci. 1992, 154, 434–443. [Google Scholar] [CrossRef]
- Kowalczyk, D.; Skrzypek, T.; Basiura-Cembala, M.; Łupina, K.; Mężyńska, M. The effect of potassium sorbate on the physicochemical properties of edible films based on pullulan, gelatin and their blends. Food Hydrocoll. 2020, 105, 105837. [Google Scholar] [CrossRef]
- Jouki, M.; Khazaei, N.; Ghasemlou, M.; HadiNezhad, M. Effect of glycerol concentration on edible film production from cress seed carbohydrate gum. Carbohydr. Polym. 2013, 96, 39–46. [Google Scholar] [CrossRef]
- Kowalczyk, D.; Gustaw, W.; Świeca, M.; Baraniak, B. A study on the mechanical properties of pea protein isolate films. J. Food Process. Preserv. 2014, 38, 1726–1736. [Google Scholar] [CrossRef]
- Basiak, E.; Lenart, A.; Debeaufort, F. How Glycerol and Water Contents Affect the Structural and Functional Properties of Starch-Based Edible Films. Polymers 2018, 10, 412. [Google Scholar] [CrossRef]
- Farahnaky, A.; Saberi, B.; Majzoobi, M. Effect of Glycerol on Physical and Mechanical Properties of Wheat Starch Edible Films. J. Texture Stud. 2013, 44, 176–186. [Google Scholar] [CrossRef]
- Misic, C.; Harriague, A. Development of marine biofilm on plastic: Ecological features in different seasons, temperatures, and light regimes. Hydrobiologia 2019, 835, 129–145. [Google Scholar] [CrossRef]
- Rabin, N.; Zheng, Y.; Opoku-Temeng, C.; Du, Y.; Bonsu, E.; Sintim, H. Biofilm Formation Mechanisms and Targets for Developing Antibiofilm Agents. Future Med. Chem. 2015, 7, 493–512. [Google Scholar] [CrossRef]
- Ait-Lahsen, H.; Soler, A.; Rey, M.; De la Cruz, J.; Llobell, A. An Antifungal Exo-a-1,3-Glucanase (AGN13.1) from the Biocontrol Fungus Trichoderma harzianum. Appl. Environ. Microbiol. 2001, 67, 5833–5839. [Google Scholar] [CrossRef]
- da Silva, A.J.; Gómez-Mendoza, D.P.; Junqueira, M.; Domont, G.B.; Ximenes Ferreira Filho, E.; de Sousa, M.V.; Ricart, C.A.O. Blue native-PAGE analysis of Trichoderma harzianum secretome reveals cellulases and hemicellulases working as multienzymatic complexes. Proteomics 2012, 12, 2729–2738. [Google Scholar] [CrossRef] [PubMed]
- Elshafie, H.S.; Camele, I.; Sofo, A.; Mazzone, G.; Caivano, M.; Masi, S.; Caniani, D. Mycoremediation effect of Trichoderma harzianum strain T22 combined with ozonation in diesel-contaminated sand. Chemosphere 2020, 252, 126597. [Google Scholar] [CrossRef] [PubMed]
- Rusetskaya, V.; Różalska, S.; Słaba, M.; Bernat, P. Degradation ability of Trichoderma spp. in the presence of poly(butylene adipate-co-terephthalate) microparticles. Int. Biodeterior. Biodegrad. 2024, 193, 105829. [Google Scholar] [CrossRef]
- Mohiddin, F.; Kashmir, J.; Bashir, I.; Shahid, I.; Padder, A.; Hamid, I.; Padder, S.; Hamid, D.B. Evaluation of different substrates for mass multiplication of Trichoderma species. J. Pharmacogn. Phytochem. 2017, 6, 563–569. [Google Scholar]
- Delabona, P.; Lima, D.; Robl, D.; Rabelo, S.; Farinas, C.; Pradella, J. Enhanced cellulase production by Trichoderma harzianum by cultivation on glycerol followed by induction on cellulosic substrates. J. Ind. Microbiol. Biotechnol. 2016, 43, 617–626. [Google Scholar] [CrossRef]
- de Sousa, K.A.; da Faheina Junior, G.S.; de Azevedo, D.C.S.; Pinto, G.A.S. Optimization of Cellulase Production by Trichoderma Strains Using Crude Glycerol as a Primary Carbon Source with a 24 Full Factorial Design. Waste Biomass Valorization 2018, 9, 357–367. [Google Scholar] [CrossRef]
- Andrzejak, R.; Janowska, B. Trichoderma spp. Improves Flowering, Quality, and Nutritional Status of Ornamental Plants. Int. J. Mol. Sci. 2022, 23, 15662. [Google Scholar] [CrossRef]
- Wiater, A.; Pleszczyńska, M.; Szczodrak, J.; Janusz, G. Comparative Studies on the Induction of Trichoderma harzianum Mutanase by α-(1→3)-Glucan-Rich Fruiting Bodies and Mycelia of Laetiporus sulphureus. Int. J. Mol. Sci. 2012, 13, 9584–9598. [Google Scholar] [CrossRef]
- Cullity, B.D.; Stock, S.R. Elements of X-Ray Diffraction, 3rd ed.; Pearson: London, UK, 2001. [Google Scholar]
- Uzun, İ. Methods of determining the degree of crystallinity of polymers with X-ray diffraction: A review. J. Polym. Res. 2023, 30, 394. [Google Scholar] [CrossRef]
- Łupina, K.; Kowalczyk, D.; Lis, M.; Raszkowska-Kaczor, A.; Drozłowska, E. Controlled release of water-soluble astaxanthin from carboxymethyl cellulose/gelatin and octenyl succinic anhydride starch/gelatin blend films. Food Hydrocoll. 2021, 123, 107179. [Google Scholar] [CrossRef]
- Kowalczyk, D.; Kazimierczak, W.; Zięba, E.; Lis, M.; Wawrzkiewicz, M. Structural and Physicochemical Properties of Glycerol-Plasticized Edible Films Made from Pea Protein-Based Emulsions Containing Increasing Concentrations of Candelilla Wax or Oleic Acid. Molecules 2024, 29, 5998. [Google Scholar] [CrossRef] [PubMed]
- Schrader, M.E. Young-Dupre Revisited. Langmuir 1995, 11, 3585–3589. [Google Scholar] [CrossRef]
- ISO 846:2019; Plastics—Evaluation of the Action of Microorganisms. ISO: Geneva, Switzerland, 2019.
- Pleszczyńska, M.; Marek-Kozaczuk, M.; Wiater, A.; Szczodrak, J. Paenibacillus strain MP-1: A new source of mutanase. Biotechnol. Lett. 2007, 29, 755–759. [Google Scholar] [CrossRef] [PubMed]
- Wiater, A.; Szczodrak, J.; Pleszczyńska, M. Mutanase induction in Trichoderma harzianum by cell wall of Laetiporus sulphureus and its application for mutan removal from oral biofilms. J. Microbiol. Biotechnol. 2008, 18, 1335–1341. [Google Scholar]
- Somogyi, M. A new reagent for the determination sugars. J. Biol. Chem. 1945, 160, 61–68. [Google Scholar] [CrossRef]
- Nelson, N. A photometric adaptation of the Somogyi method for the determination of glucose. J. Biol. Chem. 1944, 153, 375–380. [Google Scholar] [CrossRef]

| Wavenumber (cm−1) | Assignment * |
|---|---|
| 3283 | ν −OH |
| 2935 | νas -CH3, -CH2 |
| 2884 | νs C-H |
| 1651 | ν C=O |
| 1451 | δas -CH2 |
| 1412 | δs -CH2, -CH3 |
| 1345 | ν C-H,C–C, -CH3 |
| 1243 | τin-plane C–OH, C-H |
| 1208 | ν C–O, C–O–C (pyranose ring) |
| 1145 | νas C–O–C, C-C (glycosidic linkage) |
| 1106 | ν C-O |
| 1067 | νC–O, CH2OH, τC-O |
| 1029 | ν C-O (α-glycosidic bond) |
| 926 | δ C–H (α anomer) |
| 850 | τout-of-planeC-H of α-glucan units |
| Raman Shift (cm−1) | Assignment * |
|---|---|
| 1519 | τin-plane -CH2 |
| 1463 | τ C-H, O-CH3, H-CH, HOC |
| 1392 | τ C-H |
| 1339 | νs COO− |
| 1258 | δ C-CH |
| 1221 | ν C-H (rings) |
| 1112 | ν C-O-C |
| 1086 | ν C-C, C-O |
| 1066 | νs C-O |
| 973 | ν C-C, C-O-C |
| 942 | ν C-H (rings) |
| 924 | δ out-of-plane C-H |
| 848 | τ C-H (α-glycosidic linkage) |
| 818 | τ out-of-plane C-H |
| 717 | τ out-of-plane C-H, νs C-H |
| 671 | τ out-of-plane C-H |
| 576 | δ C-C-C |
| 546 | δ out-of-plane C=O |
| 484 | τ C(=O)O |
| 435 | τ in-plane C-C=O |
| 416 | τ out-of-plane HCC |
| 380 | δ C-C(=O)C |
| 327 | τ out-of-plane C-C-C-C |
| 284 | δ C-C-C |
| 258 | δ -OH |
| 212 | δ in-plane C-C-C |
| 176 | δ C-C |
| Properties | Values |
|---|---|
| Thickness | 98.38 ± 7.69 |
| Rq | 26.24 ± 3.12 |
| Xc (%) | 23.1± 1.67 |
| pH | 6.96 ± 0.06 |
| Op (Abs600/mm) | 5.65 ± 0.72 |
| L* | 90.47 ± 0.80 |
| a* | −0.45 ± 0.12 |
| b* | −5.01 ± 0.23 |
| MC (%) | 46.86 ± 2.40 |
| aw | 0.48 ± 0.01 |
| WCA (o) | 53.56 ± 1.59 |
| γL (mN/m) | 116.03 ± 1.63 |
| WVP (g mm m−2 d−1 kPa−1) | 53.69 ± 3.67 |
| TS (MPa) | 1.28 ± 0.31 |
| E (%) | 10.09 ± 0.17 |
| EM (MPa) | 30.80 ± 3.18 |
| PS | 0.20 ± 0.03 |
| Enzyme | Parameter | Hydrolysis Time | ||||
|---|---|---|---|---|---|---|
| 1 h | 2 h | 3 h | 6 h | 24 h | ||
| endo-α-1,3-glucanase | Released reducing sugars (mg) | 0.065 ± 0.008 | 0.150 ± 0.011 | 0.359 ± 0.009 | 0.716 ± 0.012 | 1.368 ± 0.029 |
| Degradation (%) | 0.53 ± 0.063 | 1.22 ± 0.092 | 2.92 ± 0.074 | 5.82 ± 0.099 | 11.12 ± 0.239 | |
| exo-α-1,3-glucanase | Released reducing sugars (mg) | 0.106 ± 0.003 | 0.172 ± 0.013 | 0.269 ± 0.016 | 0.502 ± 0.016 | 2.111 ± 0.030 |
| Degradation (%) | 0.86 ± 0.021 | 1.40 ± 0.105 | 2.19 ± 0.130 | 4.08 ± 0.133 | 17.16 ± 0.241 | |
Disclaimer/Publisher’s Note: The statements, opinions and data contained in all publications are solely those of the individual author(s) and contributor(s) and not of MDPI and/or the editor(s). MDPI and/or the editor(s) disclaim responsibility for any injury to people or property resulting from any ideas, methods, instructions or products referred to in the content. |
© 2025 by the authors. Licensee MDPI, Basel, Switzerland. This article is an open access article distributed under the terms and conditions of the Creative Commons Attribution (CC BY) license (https://creativecommons.org/licenses/by/4.0/).
Share and Cite
Dariusz, K.; Gieroba, B.; Niedźwiadek, K.; Krysa, M.; Sroka-Bartnicka, A.; Waśko, A.; Ozimek, E.; Ściegienna, A.; Basiura-Cembala, M.; Kazimierczak, W.; et al. Evaluation of Film-Forming Properties of α-1,3-Glucan Obtained from “Chicken of the Woods” Mushroom (Laetiporus sulphureus): Film Development, Characterization, and Biodegradation Assessment. Molecules 2025, 30, 1619. https://doi.org/10.3390/molecules30071619
Dariusz K, Gieroba B, Niedźwiadek K, Krysa M, Sroka-Bartnicka A, Waśko A, Ozimek E, Ściegienna A, Basiura-Cembala M, Kazimierczak W, et al. Evaluation of Film-Forming Properties of α-1,3-Glucan Obtained from “Chicken of the Woods” Mushroom (Laetiporus sulphureus): Film Development, Characterization, and Biodegradation Assessment. Molecules. 2025; 30(7):1619. https://doi.org/10.3390/molecules30071619
Chicago/Turabian StyleDariusz, Kowalczyk, Barbara Gieroba, Katarzyna Niedźwiadek, Mikołaj Krysa, Anna Sroka-Bartnicka, Adam Waśko, Ewa Ozimek, Aleksandra Ściegienna, Monika Basiura-Cembala, Waldemar Kazimierczak, and et al. 2025. "Evaluation of Film-Forming Properties of α-1,3-Glucan Obtained from “Chicken of the Woods” Mushroom (Laetiporus sulphureus): Film Development, Characterization, and Biodegradation Assessment" Molecules 30, no. 7: 1619. https://doi.org/10.3390/molecules30071619
APA StyleDariusz, K., Gieroba, B., Niedźwiadek, K., Krysa, M., Sroka-Bartnicka, A., Waśko, A., Ozimek, E., Ściegienna, A., Basiura-Cembala, M., Kazimierczak, W., & Wiater, A. (2025). Evaluation of Film-Forming Properties of α-1,3-Glucan Obtained from “Chicken of the Woods” Mushroom (Laetiporus sulphureus): Film Development, Characterization, and Biodegradation Assessment. Molecules, 30(7), 1619. https://doi.org/10.3390/molecules30071619

